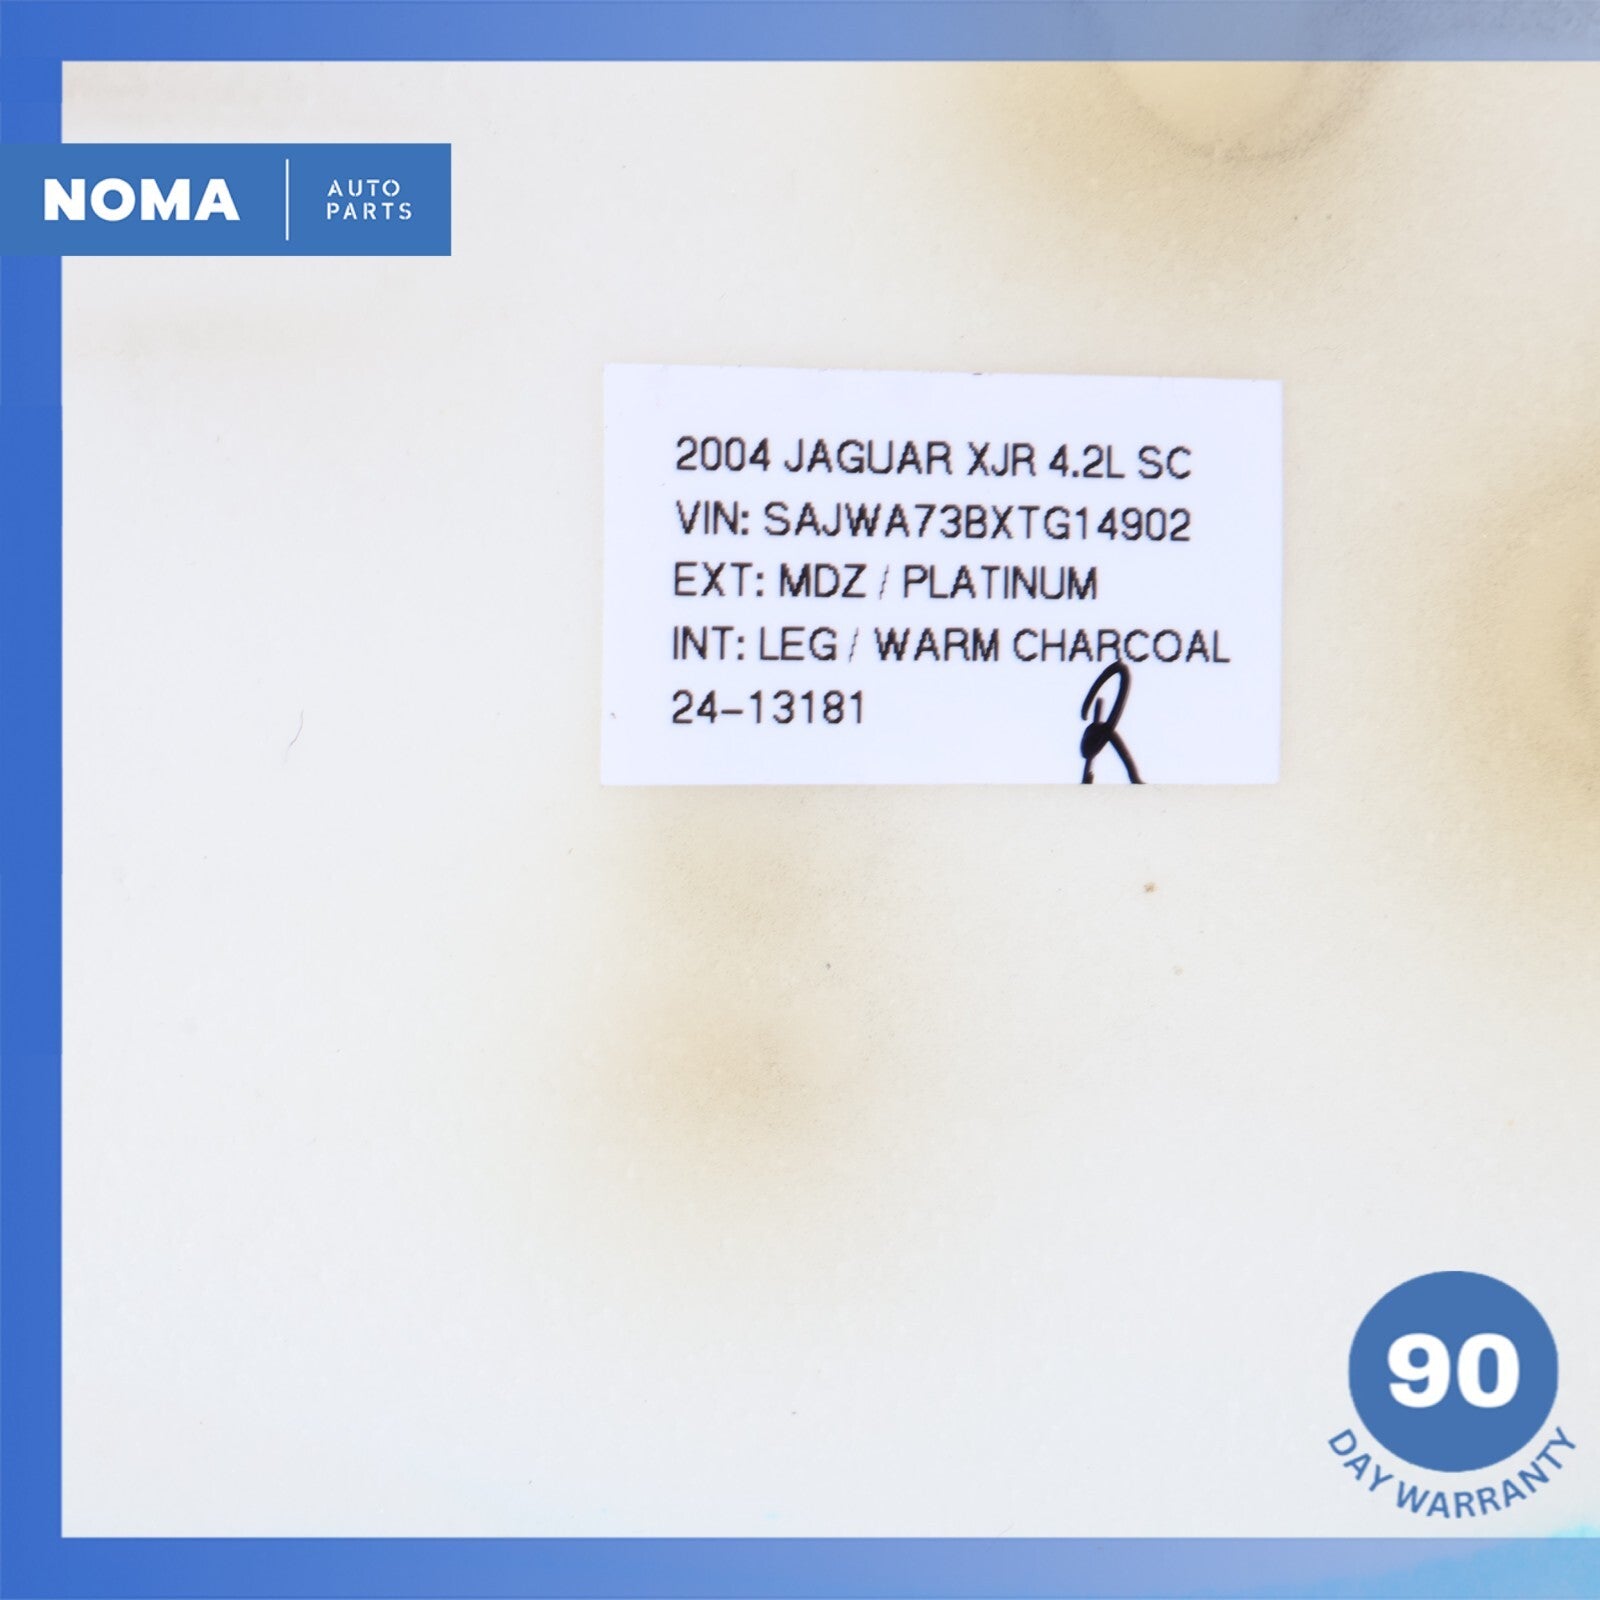

NOMA Car Parts Policies
Good / Normal Use / As shown in the photos / It is buyer's responsibility to carefully inspect all of the photos for details and/or request more photos if necessary.
- PLEASE VERIFY COMPATIBILITY BEFORE BUYING.
- IT IS THE BUYER'S RESPONSIBILITY TO DETERMINE WHETHER THE PART WILL FIT HIS/HER CAR OR NOT.
- PLEASE MAKE SURE TO MATCH THE PART NUMBER WITH YOUR ORIGINAL PART.
- WHAT YOU SEE IN THE PHOTOS IS WHAT YOU WILL RECEIVE.
- You are welcome to pick up your item at our location - please select this option during checkout
- Shipping prices for ground apply only to the continental United States. Anywhere else is considered international shipping and will have an international shipping rate.
- Process time for shipping is 1 business day for small and medium size items, and 2 business day for larger size items (Hood, Door shell, Engine, Transmission etc.)
- Any international customs fees must be paid by customer.
- Please note that we will only ship to the same billing address that payment is made from.
- Big size items like Hood, Engine or Transmission can be shipped only to business/commercial address via Freight. Shipping to Residential address will be extra cost.
- To pass our shipping savings onto you, we may alternate between FedEx or USPS or UPS depending on which is most affordable and/or faster.
- When ordering from the US, parcels may be subject to Import Tax and Duty Charges, which the Buyer is responsible to pay.
PLEASE NOTE:
Oversized items like bumpers, doors, hoods, trunk lids and other similar items will be shipped via Freight Shipping.
- All returns must be made and will be accepted within 30 days of item being received by the customer only if the item is non-functional or if it differs substantially from the description. Please, do not buy just to check and diagnose your vehicle problem.
- Please ask questions prior to bidding and verify the fit in your application with your local dealer or an independent source.
- Buyer is fully responsible for the shipping cost of the return. Shipping and handling fees are non refundable. Most of our products are offered with free shipping. Meaning shipping has been included in the price to provide you with the total cost of the order. You will be refunded the purchase price minus our shipping costs as soon as item is returned to us.
- All electronics are tested before removed from vehicle. IF NOT FUNCTIONAL, WE WILL NOT SELL. If the item is defected we will state accordingly and is sold for parts only. Please ask questions before purchasing.
- We are not liable to pay for any labor fees associated with the installation or removal of any parts we sell.
- We offer 90 DAYS WARRANTY on all our parts.
- All the parts are tested either before or after removal from the vehicle.
- Before purchasing the item, the customer MUST verify that the item will fit the said vehicle.
- Item may show light scuffs, scratches or other imperfections as a result of this being a used part.
Please contact our team If you have a questions about any part please contact us BEFORE purchasing.
Call / Text: (360) 773-2632
Email: nomaautoparts@gmail.com